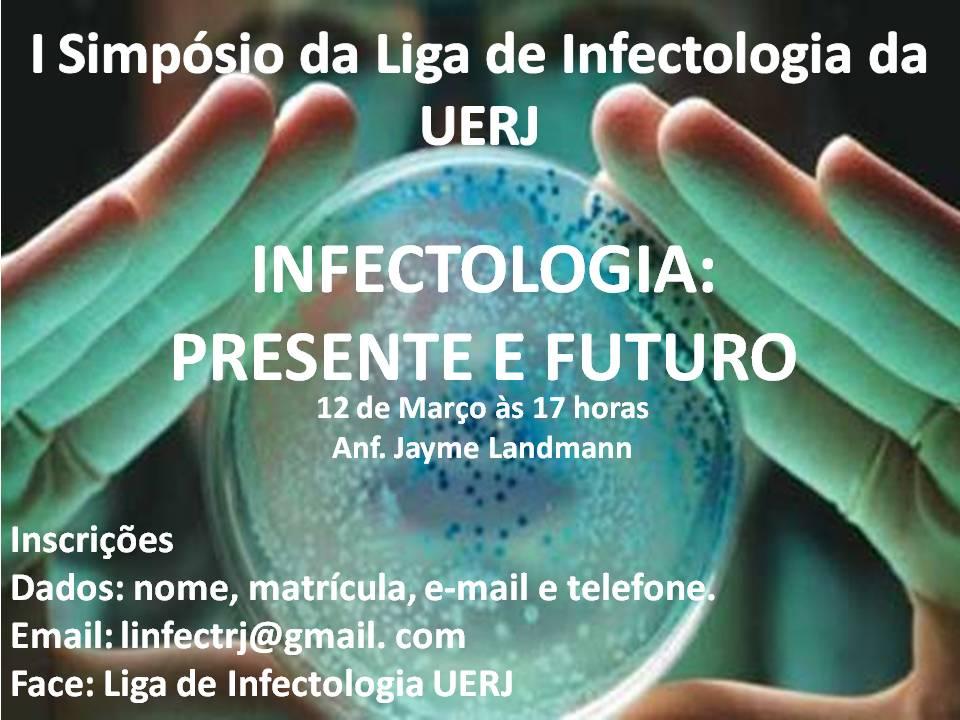

Abertura da LIGA!!!
27/02/2012 20:08
Se a única coisa que você conhece sobre infectologia, se remete ao House , venha para Abertura de LINFECT, se surpreenda e
seja infectado por essa idéia
Gestão LINFECT 2012
Local: Anfiteatro Jayme Landman, dia 12 de março às 17h.